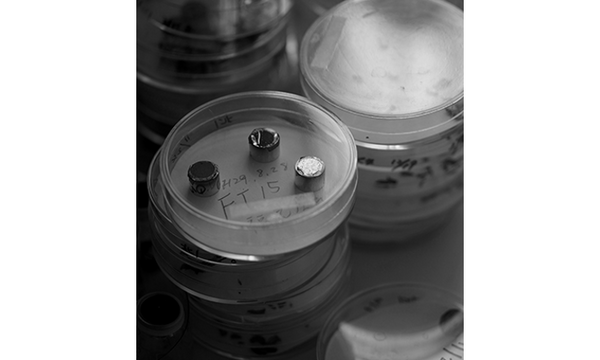

Fukumitsuya
Description

Kome Lab Sake Yeast Extract
Regular price
$30.00
Description
An extract from the miraculous yeast chosen from the cream of the crop of the sake yeast well-known amongst sake breweries. It contains balanced and abundant amounts of beauty ingredients such as amino acids from the yeast which will make your skin supple and glossy. Supplement your usual routine, and you will feel the difference in moisturization.
How to Use
Facewash⇒ This product ⇒ Face lotion ⇒ milk lotion/ cream
1. To make it easier to apply, first warm an adequate amount in your palm.
2. Apply to face as if covering whole face in palm.
Ingredients
Water, BG, yeast extract
Manufacture